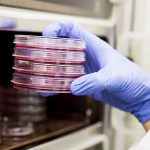
Nanomachines drill holes into cancer cells, Says New Study Nanomachines drill holes into cancer cells, Says New Study

Fasting on and off could help prevent obesity, Says New Study
A new study suggests that intermittent fasting (IF), without restricting overall calorie intake, can help reduce weight, fight obesity and metabolic diseases.
Intermittent fasting has...
Scientists claim to have identified a cause and a cure for dyslexia
A pair of French scientists have identified a tiny discrepancy in the eyes of people with dyslexia, potentially making it treatable.
Writing in the Proceedings...
Eating banana and avocado daily cuts risk of heart attack, a new study reveals
Eating one banana and an avocado a day may prevent hardening of the arteries that can result in heart disease and death, says new...
Canadian woman gets eye tattooed and it goes horribly wrong
Canadian model has been left partially blinded after a botched eye tattoo; an experience which has left her considering taking her own life.
Bad reactions...
After 15 Years in a Vegetative State, Researchers Partly Restore Consciousness in Patient
A car crash victim left in a coma for 15 years has shown signs of life after a nerve stimulator was implanted into his...
World’s Ex Heaviest Woman Dies In Abu Dhabi Due To ‘Health Complications’
Egyptian Eman Ahmed, dubbed the world’s heaviest woman, died today at an Abu Dhabi hospital, merely a week after she turned 37.
A statement from...
Facial Structure Linked To Sexual Drive, A New Study Reveals
New study from Nipissing University in Ontario, Canada and published in the journal Archives of Sexual Behavior found that men and women with shorter,...
McGill Uni says eating protein is key to muscle in old age
Researchers link protein distribution to greater mass and muscle strength in the elderly. a new Canadian study has found that splitting protein equally across...
Nanomachines drill holes into cancer cells, Says New Study
Nanomachines which can drill into cancer cells, killing them in just 60 seconds, have been developed by researchers.
Scientists from the UK’s Durham University and...
Missing Man Found Dead Inside Giant Python (Watch)
A man who went missing in Indonesia earlier this week was near his own garden — inside the stomach of a 20-foot long snake.
The...
Top News
Hey ISIS, You Suck: Local Muslims Post Anti-ISIS Billboard
A new billboard on Manchester Road in Missouri reads, "HEY ISIS, YOU SUCK!!! From: #ActualMuslims."
A group of Muslim-Americans have put up a blunt billboard...